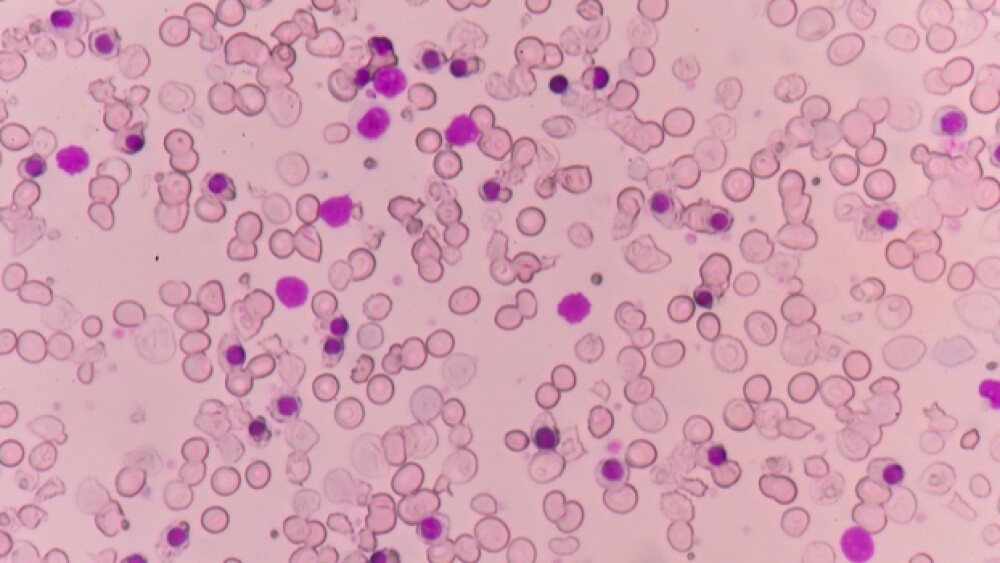

The approval marks the first approved treatment in the United States for this condition.
The U.S. Food and Drug Administration (FDA) approved Celgene and Acceleron Pharma’s Reblozyl for the treatment of anemia in adult patients with beta thalassemia who require regular red blood cell (RBC) transfusions. The approval marks the first approved treatment in the United States for this condition.
The approval also marks the first for Acceleron, which sent shares up nearly 7% in afternoon trading. Reblozyl, an erythroid maturation agent, was approved under Fast Track Designation and the drug received Orphan Drug designation.
With the approval, Reblozyl (luspatercept-aamt) becomes a new therapeutic class for beta thalassemia patients. Reblozyl works by regulating late-stage red blood cell maturation to help patients reduce their RBC transfusion burden. The drug is not indicated for use as a substitute for RBC transfusions in patients who require immediate correction of anemia, Celgene stressed in its Friday afternoon announcement.
Nadim Ahmed, president of Celgene’s global hematology and oncology unit, said the approval of the new medication is an important milestone for patients with this hematological disorder. Beta thalassemia is a rare, inherited blood disorder caused by a genetic defect in hemoglobin. The disease is associated with ineffective erythropoiesis, which results in the production of fewer and less healthy RBCs, often leading to severe anemia – a condition that can be debilitating and can lead to more severe complications for patients, as well as other serious health issues.
“There are very limited options for patients living with anemia due to beta thalassemia who are dependent on long term red blood cell transfusions. We are pleased to make REBLOZYL available as a new therapy for these patients to help address their anemia, a significant clinical complication of beta thalassemia,” Ahmed said in a statement.
Habib Dable, president and chief executive officer of Acceleron, the co-developer of Reblozyl, touted the approval as a milestone for patients as well as for the company.
“We are enormously grateful to the patients, families and caregivers who participated in and supported our research. Their contributions have been essential in helping to ensure that Reblozyl would emerge successfully from our longstanding collaboration with Celgene,” Dable said in a statement.
Reblozyl was approved based on data from the Phase III BELIEVE trial. The trial achieved a clinically meaningful and statistically significant improvement in the primary endpoint. Data showed that 21% of the patients who received Reblozyl achieved at least a 33% reduction in transfusions compared to 4.5% of the patients who received a placebo. The transfusion reduction meant that the patient needed fewer transfusions over 12 consecutive weeks while taking Reblozyl, the FDA said in its announcement.
The study also met key secondary endpoints, including transfusion burden reduction of at least 33% during weeks 37 to week 48. This was achieved in 19.6% of patients in the Reblozyl arm and 3.6% in the placebo arm, Celgene and Acceleron said. Other efficacy endpoints included transfusion burden reduction of more than 50% during weeks 13-24 and weeks 37-48. Also, a greater than 50% reduction in transfusion burden was observed in 7.6% of patients receiving Reblozyl versus 1.8% of placebo patients.
Common side effects for patients taking Reblozyl were headache, bone pain, joint pain, fatigue, cough, abdominal pain, diarrhea and dizziness.
Celgene and Acceleron anticipate Reblozyl will be available within one week of its approval.
Reblozyl is also being evaluated by the FDA for another condition, myelodysplastic syndrome, or MDS. The FDA is currently reviewing Reblozyl as a treatment of anemia in adult patients with very low to immediate-risk MDS who have ring sideroblasts and require RBC transfusions. That review is based on the Phase III MEDALIST trial. In that trial, luspatercept achieved a highly statistically significant improvement in the primary endpoint of red blood cell (RBC) transfusion independence of at least eight consecutive weeks of treatment during the first 24 weeks of treatment compared to placebo.